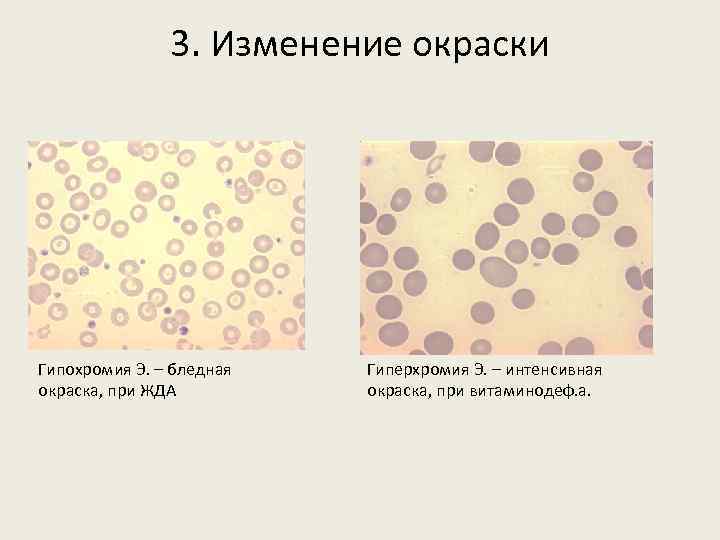
3. Изменение окраски Гипохромия Э. – бледная окраска, при ЖДА Гиперхромия Э. – интенсивная
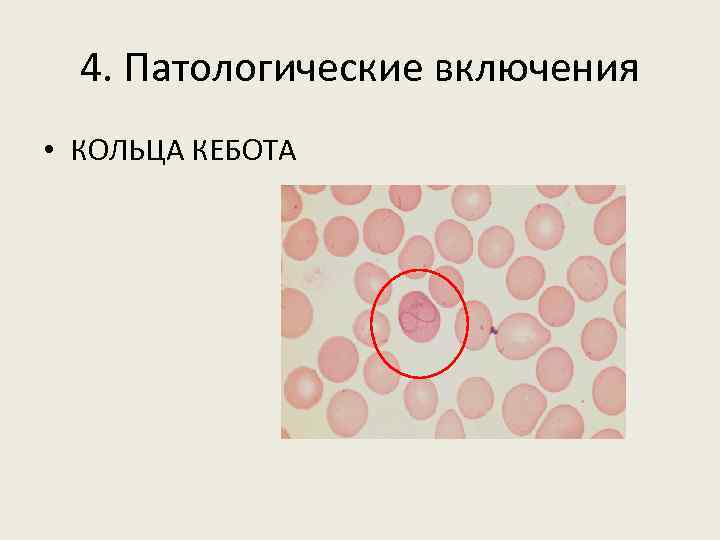
4. Патологические включения • КОЛЬЦА КЕБОТА
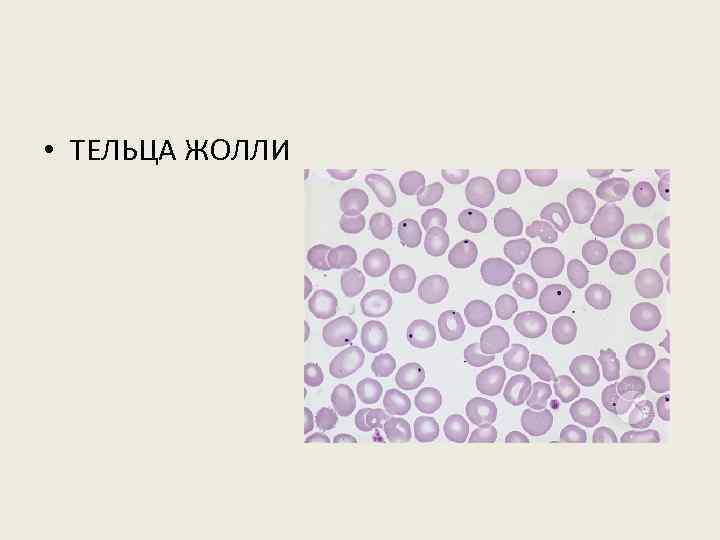
• ТЕЛЬЦА ЖОЛЛИ

АнЕМИЯ, ЛЕЙКОЦИТОЗ -для практического занятия.pptx
- Количество слайдов: 24
 ПАТОЛОГИЧЕСКАЯ ФИЗИОЛОГИЯ СИСТЕМЫ КРОВИ
ПАТОЛОГИЧЕСКАЯ ФИЗИОЛОГИЯ СИСТЕМЫ КРОВИ
 МОРФОЛОГИЯ ЭРИТРОЦИТОВ Мазок крови человека. Гематоксилин и эозин
МОРФОЛОГИЯ ЭРИТРОЦИТОВ Мазок крови человека. Гематоксилин и эозин
 РЕГЕНЕРАТОРНЫЕ ФОРМЫ ЭРИТРОЦИТОВ (клетки физиологической регенерации) Молодые незрелые клетки крови, поступление которых в периферическую кровь говорит об усиленной регенерации эритроцитов.
РЕГЕНЕРАТОРНЫЕ ФОРМЫ ЭРИТРОЦИТОВ (клетки физиологической регенерации) Молодые незрелые клетки крови, поступление которых в периферическую кровь говорит об усиленной регенерации эритроцитов.
 РЕГЕНЕРАТОРНЫЕ ФОРМЫ ЭРИТРОЦИТОВ РЕТИКУЛОЦИТЫ ПОЛИХРОМАТОФИЛЫ НОРМОБЛАСТЫ
РЕГЕНЕРАТОРНЫЕ ФОРМЫ ЭРИТРОЦИТОВ РЕТИКУЛОЦИТЫ ПОЛИХРОМАТОФИЛЫ НОРМОБЛАСТЫ
 ДЕГЕНЕРАТИВНЫЕ ФОРМЫ ЭРИТРОЦИТОВ (качественные изменения эритроцитов, говорят о неполноценности клеток) 1. Анизоцитоз (изменение величины) Микроцитоз (железодефицитная анемия) Макроцитоз (В-12 фолиеводеф. анемия)
ДЕГЕНЕРАТИВНЫЕ ФОРМЫ ЭРИТРОЦИТОВ (качественные изменения эритроцитов, говорят о неполноценности клеток) 1. Анизоцитоз (изменение величины) Микроцитоз (железодефицитная анемия) Макроцитоз (В-12 фолиеводеф. анемия)
 2. Пойкилоцитоз (изменение формы Э. ) Овалоциты Мишеневидные Э. Стоматоциты Звездчатые Э.
2. Пойкилоцитоз (изменение формы Э. ) Овалоциты Мишеневидные Э. Стоматоциты Звездчатые Э.
3. Изменение окраски Гипохромия Э. – бледная окраска, при ЖДА Гиперхромия Э. – интенсивная окраска, при витаминодеф. а.
3. Изменение окраски Гипохромия Э. – бледная окраска, при ЖДА Гиперхромия Э. – интенсивная окраска, при витаминодеф. а.
4. Патологические включения • КОЛЬЦА КЕБОТА
4. Патологические включения • КОЛЬЦА КЕБОТА
• ТЕЛЬЦА ЖОЛЛИ
• ТЕЛЬЦА ЖОЛЛИ
 БАЗОФИЛЬНАЯ ЗЕРНИСТОСТЬ
БАЗОФИЛЬНАЯ ЗЕРНИСТОСТЬ
 ЛЕЙКОЦИТОЗЫ С/Х ЖИВОТНЫХ
ЛЕЙКОЦИТОЗЫ С/Х ЖИВОТНЫХ

 Морфология лейкоцитов крови у животных разных видов Нейтрофилы: • Юные (метамиелоциты)– бобовидное ядро фиолетового цвета, цитоплазма розовая, нежная зернистость розового цвета. У взрослых здоровых животных в периферической крови, как правило, не обнаруживаются. • Палочкоядерные – зрелая форма, у здоровых животных постоянно обнаруживают в крови; ядро в виде палочки, подковы, буквы S, темно-фиолетовое, цитоплазма розово-голубого цвета с мелкой розовато-голубоватой зернистостью (часто плохо видна). • Сегментоядерные – отличаются от палочкоядерных характером ядра, оно состоит из 2 -5 сегментов, между которыми есть перемычки; темно-фиолетовое ядро.
Морфология лейкоцитов крови у животных разных видов Нейтрофилы: • Юные (метамиелоциты)– бобовидное ядро фиолетового цвета, цитоплазма розовая, нежная зернистость розового цвета. У взрослых здоровых животных в периферической крови, как правило, не обнаруживаются. • Палочкоядерные – зрелая форма, у здоровых животных постоянно обнаруживают в крови; ядро в виде палочки, подковы, буквы S, темно-фиолетовое, цитоплазма розово-голубого цвета с мелкой розовато-голубоватой зернистостью (часто плохо видна). • Сегментоядерные – отличаются от палочкоядерных характером ядра, оно состоит из 2 -5 сегментов, между которыми есть перемычки; темно-фиолетовое ядро.
 Эозинофилы: • Палочкоядерный – имеет ядро как у нейтрофилов, в виде палочки или жгута различной изогнутости. Цитоплазма заполнена эозинофильной (ярко-розовой) зернистостью. • Сегментоядерный – ядро, состоит только из двух круглых или каплеобразных частей.
Эозинофилы: • Палочкоядерный – имеет ядро как у нейтрофилов, в виде палочки или жгута различной изогнутости. Цитоплазма заполнена эозинофильной (ярко-розовой) зернистостью. • Сегментоядерный – ядро, состоит только из двух круглых или каплеобразных частей.
 Базофилы: • Палочкоядерный –крупная базофильная зернистость (темно-фиолетовая, бордовая) заполняет всю цитоплазму и часто накладывается на ядро, поэтому контуры ядра становятся расплывчатыми. • Сегментоядерный базофил – имеет лапчатую или округлую форму, двух - четырехлопастное ядро. Крупная базофильная зернистость густо покрывает всю клетку. Гранулы, в зависимости от вида животных, имеют сине фиолетовый или коричнево черный цвет.
Базофилы: • Палочкоядерный –крупная базофильная зернистость (темно-фиолетовая, бордовая) заполняет всю цитоплазму и часто накладывается на ядро, поэтому контуры ядра становятся расплывчатыми. • Сегментоядерный базофил – имеет лапчатую или округлую форму, двух - четырехлопастное ядро. Крупная базофильная зернистость густо покрывает всю клетку. Гранулы, в зависимости от вида животных, имеют сине фиолетовый или коричнево черный цвет.
 • Моноциты – самые крупные клетки периферической крови, округлой или неправильной формы, ядро - в виде подковы, бабочки, боба, неравномерно окрашивается в слабо-фиолетовый цвет с темно-фиолетовыми пятнами; цитоплазма серо-голубая.
• Моноциты – самые крупные клетки периферической крови, округлой или неправильной формы, ядро - в виде подковы, бабочки, боба, неравномерно окрашивается в слабо-фиолетовый цвет с темно-фиолетовыми пятнами; цитоплазма серо-голубая.
 • Лимфоциты – по величине разделяют на малые, средние и большие. Ядро круглое темно-фиолетовое; цитоплазма – слабоголубого цвета. У малых лимфоцитов ее может быть очень мало. У здоровых животных в периферической крови преобладают малые лимфоциты.
• Лимфоциты – по величине разделяют на малые, средние и большие. Ядро круглое темно-фиолетовое; цитоплазма – слабоголубого цвета. У малых лимфоцитов ее может быть очень мало. У здоровых животных в периферической крови преобладают малые лимфоциты.
 ЛЕЙКОЦИТАРНАЯ ФОРМУЛА* – это процентное соотношение различных видов лейкоцитов, записанное в определенном порядке. * - таблицу не зарисовывать
ЛЕЙКОЦИТАРНАЯ ФОРМУЛА* – это процентное соотношение различных видов лейкоцитов, записанное в определенном порядке. * - таблицу не зарисовывать
 НЕЙТРОФИЛЬНЫЙ ЛЕЙКОЦИТОЗ Сдвиг лейкоцитарной формулы (ядерный сдвиг) – нарушение соотношения между незрелыми и зрелыми формами нейтрофилов. Увеличение содержания в крови молодых форм нейтрофильных гранулоцитов свидетельствует о ядерном сдвиге влево, преобладание зрелых нейтрофилов с большим колвом сегментов (5 -6) на фоне исчезновения более молодых клеток – о ядерном сдвиге вправо.
НЕЙТРОФИЛЬНЫЙ ЛЕЙКОЦИТОЗ Сдвиг лейкоцитарной формулы (ядерный сдвиг) – нарушение соотношения между незрелыми и зрелыми формами нейтрофилов. Увеличение содержания в крови молодых форм нейтрофильных гранулоцитов свидетельствует о ядерном сдвиге влево, преобладание зрелых нейтрофилов с большим колвом сегментов (5 -6) на фоне исчезновения более молодых клеток – о ядерном сдвиге вправо.
 ЭОЗИНОФИЛЬНЫЙ ЛЕЙКОЦИТОЗ Увеличение содержания эозинофилов в крови. • Аллергические реакции • Паразитарные заболевания (фасциолез, эймериоз, трихинелллез и т. д. ) • Рожа свиней • Переход острого процесса в хронический
ЭОЗИНОФИЛЬНЫЙ ЛЕЙКОЦИТОЗ Увеличение содержания эозинофилов в крови. • Аллергические реакции • Паразитарные заболевания (фасциолез, эймериоз, трихинелллез и т. д. ) • Рожа свиней • Переход острого процесса в хронический
 БАЗОФИЛЬНЫЙ ЛЕЙКОЦИТОЗ Бывает у животных очень редко • Миелоидный лейкоз • Аллергия • Введение сывороток • Может сопровождать эозинофилию при гельминтозах
БАЗОФИЛЬНЫЙ ЛЕЙКОЦИТОЗ Бывает у животных очень редко • Миелоидный лейкоз • Аллергия • Введение сывороток • Может сопровождать эозинофилию при гельминтозах
 МОНОЦИТОЗ
МОНОЦИТОЗ
 ЛИМФОЦИТОЗ
ЛИМФОЦИТОЗ
 МОРФОЛОГИЯ НЕЙТРОФИЛОВ ПРИ ПАТОЛОГИИ Дегенеративные изменения нейтрофилов возникают при различных патологических состояниях (инфекциях, воздействии химических веществ, заболеваниях кроветворного аппарата, действии проникающих излучений, попадании внутрь радиоактивных веществ) и могут затрагивать ядро и цитоплазму. Морфологические изменения цитоплазмы представляют собой дефекты созревания, возникающие в результате создавшихся в костном мозге «токсических условий» . К ним относят: • 1. Цитоплазматические вакуоли (пенистая базофилия); • 2. Токсическая (токсогенная) зернистость; • 3. Тельца (включения) Деле (Князькова-Деле, Доули); • 4. Гиперсегментация сегментоядерных нейтрофилов; • 5. Гипосегментация ядра (пельгероид, псевдопельгеровская аномалия); • 6. Пикноз, кариорексис, цитолиз.
МОРФОЛОГИЯ НЕЙТРОФИЛОВ ПРИ ПАТОЛОГИИ Дегенеративные изменения нейтрофилов возникают при различных патологических состояниях (инфекциях, воздействии химических веществ, заболеваниях кроветворного аппарата, действии проникающих излучений, попадании внутрь радиоактивных веществ) и могут затрагивать ядро и цитоплазму. Морфологические изменения цитоплазмы представляют собой дефекты созревания, возникающие в результате создавшихся в костном мозге «токсических условий» . К ним относят: • 1. Цитоплазматические вакуоли (пенистая базофилия); • 2. Токсическая (токсогенная) зернистость; • 3. Тельца (включения) Деле (Князькова-Деле, Доули); • 4. Гиперсегментация сегментоядерных нейтрофилов; • 5. Гипосегментация ядра (пельгероид, псевдопельгеровская аномалия); • 6. Пикноз, кариорексис, цитолиз.


